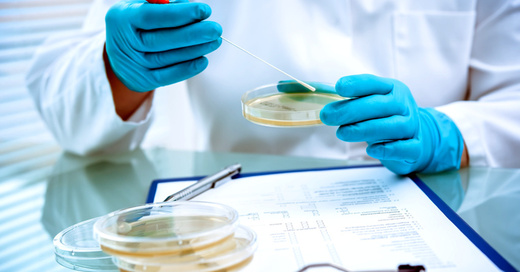

Tag Archiv: Salmonellen
 12. Dezember 2022
Eier aus dem Kreis Waldshut wegen Salmonellen-Gefahr zurückgerufen
Die betroffenen Eier wurden vor allem an Geschäfte im Landkreis ausgeliefert (…)
12. Dezember 2022
Eier aus dem Kreis Waldshut wegen Salmonellen-Gefahr zurückgerufen
Die betroffenen Eier wurden vor allem an Geschäfte im Landkreis ausgeliefert (…)
 07. April 2022
Ferrero weitet Produktrückruf von Kinder-Produkten noch einmal aus
Wegen eines Salmonellen-Verdachts lässt der Hersteller immer mehr Schoko-Produkte aus den Regalen nehmen. (…)
07. April 2022
Ferrero weitet Produktrückruf von Kinder-Produkten noch einmal aus
Wegen eines Salmonellen-Verdachts lässt der Hersteller immer mehr Schoko-Produkte aus den Regalen nehmen. (…)
 11. April 2019
Vorsicht vor Bakterien beim Ostereier auspusten
Bereits kleine Mengen Salmonellen können für Kinder gefährlich werden. (…)
11. April 2019
Vorsicht vor Bakterien beim Ostereier auspusten
Bereits kleine Mengen Salmonellen können für Kinder gefährlich werden. (…)
 23. Mai 2018
Kaufland nimmt Mandeln wegen Salmonellen-Verdachts aus den Regalen
Wer das betroffene Produkt bereits gekauft hat, soll in ganz Deutschland sein Geld dafür zurück erhalten. (…)
23. Mai 2018
Kaufland nimmt Mandeln wegen Salmonellen-Verdachts aus den Regalen
Wer das betroffene Produkt bereits gekauft hat, soll in ganz Deutschland sein Geld dafür zurück erhalten. (…)
 10. August 2016
Freiburger Hygiene-Experte warnt vor Soda-Sprudlern
In den Geräten können sich Keime schlagartig vermehren und die Gesundheit gefährden. (…)
10. August 2016
Freiburger Hygiene-Experte warnt vor Soda-Sprudlern
In den Geräten können sich Keime schlagartig vermehren und die Gesundheit gefährden. (…)
 27. Juli 2016
Der „Grill-Keim“ hat momentan wieder Hochsaison
Mediziner warnen zur Grillsaison wieder vor dem kleinen Bruder der Salmonellenvergiftung. (…)
27. Juli 2016
Der „Grill-Keim“ hat momentan wieder Hochsaison
Mediziner warnen zur Grillsaison wieder vor dem kleinen Bruder der Salmonellenvergiftung. (…)
 16. Februar 2016
Salmonellengefahr – Kaufland ruft K-Classic Gourmet Salami zurück
Erstattung des Kaufpreises, auch ohne Vorlage des Kassenbons. (…)
16. Februar 2016
Salmonellengefahr – Kaufland ruft K-Classic Gourmet Salami zurück
Erstattung des Kaufpreises, auch ohne Vorlage des Kassenbons. (…)
 16. September 2015
Ursache für Salmonellen-Ausbruch im Kreis Emmendingen bleibt unklar
Die Staatsanwaltschaft hat keine Hinweise dafür gefunden, dass die Salmonellen für den Tod zweier Senioren verantwortlich sind. (…)
17. August 2015
Staatsanwaltschaft ermittelt nach tödlicher Salmonellen-Infektion im Kreis Emmendingen
Nach dem Tod zweier Senioren geht es um den Verdacht der fahrlässigen Tötung und Körperverletzung. (…)
16. September 2015
Ursache für Salmonellen-Ausbruch im Kreis Emmendingen bleibt unklar
Die Staatsanwaltschaft hat keine Hinweise dafür gefunden, dass die Salmonellen für den Tod zweier Senioren verantwortlich sind. (…)
17. August 2015
Staatsanwaltschaft ermittelt nach tödlicher Salmonellen-Infektion im Kreis Emmendingen
Nach dem Tod zweier Senioren geht es um den Verdacht der fahrlässigen Tötung und Körperverletzung. (…)
14. August 2015
Sozialministerium fordert Bericht nach Salmonellen-Ausbruch im Raum Emmendingen
Zwei Menschen waren in Altenpflegeheimen in Endingen und Rheinhausen an der Krankheit gestorben. (…)
14. August 2015
Sozialministerium fordert Bericht nach Salmonellen-Ausbruch im Raum Emmendingen
Zwei Menschen waren in Altenpflegeheimen in Endingen und Rheinhausen an der Krankheit gestorben. (…)
 13. August 2015
Ursache für tödlichen Salmonellen-Ausbruch im Raum Emmendingen unklar
Jetzt prüft das Landesgesundheitsamt Essensproben aus den betroffenen Pflegeheimen. (…)
21. Mai 2015
Eierproduzent aus Bayern soll Schuld an Salmonellen-Epidemie sein
Über 500 Menschen waren letztes Jahr europaweit erkrankt, zwei von ihnen sind sogar gestorben. (…)
13. August 2015
Ursache für tödlichen Salmonellen-Ausbruch im Raum Emmendingen unklar
Jetzt prüft das Landesgesundheitsamt Essensproben aus den betroffenen Pflegeheimen. (…)
21. Mai 2015
Eierproduzent aus Bayern soll Schuld an Salmonellen-Epidemie sein
Über 500 Menschen waren letztes Jahr europaweit erkrankt, zwei von ihnen sind sogar gestorben. (…)